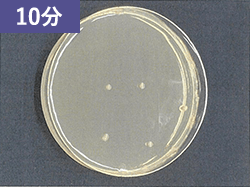
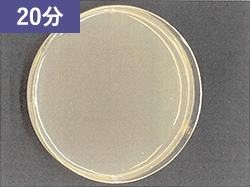
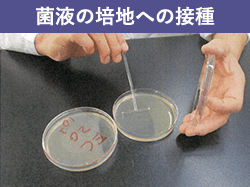

JOKIN99 M-560深紫外線照射型キーボード除菌機 JOKIN99 M-560

オフィス・ネットカフェ・図書館などに最適!
共用PCの除菌に JOKIN99 M-560!
パソコン除菌でこんなお悩みありませんか?
- 沢山の人が共有で使用する
キーボードの除菌が大変 - 何台もあるパソコン全てを除菌するのに
時間がかかる - できる限り手軽に、
でもしっかり除菌がしたい

深紫外線照射型キーボード除菌機JOKIN99 M-560がお悩みを解決!
アルコール除菌がし辛い多くの人が触れる
共有キーボードは定期的な除菌がお勧めです。
- 休憩時に
- 昼食中に
- 仕事終わりに

JOKIN99 M-560の特徴
-
強い殺菌性能!
20分の照射で99%の除菌が可能!20分放置すれば、99%の殺菌が可能。20分でオートオフの機能がついています。
-
凸凹に影響を受けにくい=広い方射角
発光ランプ6 本を配置することにより、点光源のLEDと異なり広い放射角で拡散発光し、凸凹があるものでも、影ができにくく、安定した除菌が可能。
-
マウスも除菌可能なワイドサイズ
(内寸560mm)テンキー搭載のワイドキーボード+マウスも楽々入るワイドサイズ!
-
USBからの直接給電でどこでも使用可能
USB(2.0,3.0)での給電の為ACアダプターが不要、PCがあればどこでも使用可能です。
-
人体への安全性=弱い紫外線の長時間照射
USB給電による弱い紫外線量の為、直接・長時間浴びなければ安心・安全!
製品サイズ

使用例




効果測定
食品衛生登録検査機関「一般社団法人 愛知県薬剤師会生活科学センター」に依頼し
下記のような試験結果を得ました!
表「JOKIN99 M-560」による除菌効果
| UV 照射時間とコロニー数 | |||
|---|---|---|---|
| 0 分 | 10 分 | 20 分 | |
| 大腸菌 | 1.1×10⁷ | 5 | 2 |
| 黄色ブドウ球菌 | 6.7 x 10⁷ | 10 | 2 |
(単位:CFU)


試験結果
[ 大腸菌に対する除菌効果 ]
[ 黄色ブドウ球菌に対する除菌効果 ]
[ 作業工程 ]
よくある質問
- 深紫外線(UVC)とはなんでしょうか?
- 深紫外線は、紫外線の中でも波長が短く可視光線よりも波長が短い光で、特に100~315nmの波長域のものを指します。
波長別に315~400nmの「UV-A」、280~315nmの「UV-B」、100~280nmの「UV-C」(深紫外)の3種類に分類され、UVBとUVCが深紫外線と呼ばれます。
このうち最もエネルギーが高く、生体に対する強い破壊力を持つのがUV-Cで、その特性を活かし、医療機器や工場、研究機関、食品分野など主に業務用の殺菌や検査用途に利用されており、生活面でもトイレ、キッチン、調理器具などの殺菌・消臭や水の浄化、空気の除菌などで使用されています。なお当製品は260nmの波長のUVCを発生させています。 - 深紫外線(UVC)は自然界には無いのでしょうか?
- 太陽光線には、本可視光線だけではなく紫外線や赤外線などの電磁波が含まれています。太陽光線は地表に達する前にオゾン層を通過するので、太陽光線に含まれる短波長の紫外線(UV-C)は、ほとんどオゾン層によって吸収され、地表に到達する紫外線は比較的波長の長いUV-A、UV-Bだけとなります。
- 深紫外線は人体に悪いのではないでしょうか?
- 確かに320nm以下の紫外線(UV-B・UV-C)は、目の障害、紅斑や皮膚のDNA損傷による癌の誘発などがあげられます。
これらの光源を裸眼で直接見たり、無防備で人体を曝すことは危険な行為となります。
JIS規格の安全基準では殺菌灯(254nm 水銀ランプ)の人体への照射限界を参考にすると、JIS Z 8812(有害紫外線放射の測定方法)により、許容限界値(TLV)は1日8時間以内で60J/m2以下の照射量と規定されています。
採用しているモジュールでは、照度の強い中央部分(100μW/cm2)に手を入れると1分間で許容限界値となりますが、意図的にUVCを当てようとしない限り、1分間もUVC照射することは無いので、安全に使うことができます。
また、除菌器の外側に漏れるUVCがあっても、30μW/cm2よりも低い照度ですので、意図的に長時間近づかない限り安全です。 - オゾンは発生しないのでしょうか?
- 当製品は260nmの波長のUVCを利用しています。オゾンは240nm未満の波長で生成されますので殆ど発生することはございません。その為金属が錆びる腐食の悪影響は殆どございません。
- トラブルの際はどうすればよろしいのでしょうか?
- テキ購入会社様もしくは株式会社光製作所にお問い合わせください。
- 保障について
- 〇保証期間
保証期間は、お買い上げ後1年間です。
〇保証範囲
取扱説明書、本体貼り付けラベル等の注意書に従った使用状態で保証期間内に故障した場合には、無償修理させていただきます。
〇保証の免責事項
保証期間内でも次の場合には原則として有料とさせていただきます。
(1)使用上の誤り及び不当な修理や改造による故障及び損傷
(2)お買い上げ後の取り付け場所の移動、輸送、落下などによる故障及び損傷
(3)異常な仕様に起因する故障や不具合
〇製品保証について
上記保証期間中に当社側の責任による故障が発生した場合は、製品の故障部分の交換または修理を無償で実施いたします。通常の保証は製品のみの保証となっておりますので、ご返送の際にかかる送料はお客様にご負担して頂きます。しかし、修理後の発送は送料無料です。
紫外線の安全性について
紫外線UVCは菌やウイルスなど細胞が持つDNAやRNAに吸収される性質を持ちます。
紫外線を吸収した細胞のDNA組織のらせん構造は破壊され、二量体(シクロブタンピリミジン)を形成し、生殖能力を失います。
そして死滅します。これが紫外線による殺菌、ウイルスの不活化のメカニズムです。
よって、原理的に殺菌や不活化が難しい菌やウイルスは存在しません。また、薬剤耐性菌のような変異や耐性化を心配することも不要と言えます。「光」を用いることで、非加熱・非接触・ノンケミカルな殺菌が可能になります。
公立大学法人 奈良県立医科大学 微生物感染学講座の発表により新型コロナウイルスの不活性化には約2万マイクロジュール(uj)㎝平方 紫外線照射量は必要とのことです。
今回のキーボード除菌器内では、UVC照度が強いUVC発光素子直下50mmの位置で100μW/cm2、照度が弱い端の部分で30μW/cm2程度と設定しています。
その為照度が弱い外縁部においては2万マイクロジュール/㎝2の紫外線照射量で99%不活化は、20,000÷30μ = 667秒
(約11分)強い発光素子直下では20,000÷100μ=200秒(3分20秒)で99%の不活化が想定されますが、安全度を考慮して除菌タイムは20分と推奨しています。
一般的に紫外線は人体に悪影響を及ぼします。
◇除菌に効果のあるUVC領域の紫外線は人体にも影響があり注意が必要です。
◇従来からある殺菌灯(水銀ランプ)は人体に対する照射限界が定められています。
◇目に刺激があり、炎症を起こすので注意が必要です。
殺菌灯(254nm 水銀ランプ)の人体への照射限界を参考にすると、
JIS Z 8812(有害紫外線放射の測定方法)により、許容限界値(TLV)は1日8時間以内で60J/m2以下の照射量と規定されています。
8時間照射で60J/m2以下の照射量となるUVC照度は0.2μW/cm2以下となりますが、8時間のところを分単位、秒単位に置き換えると、限界値は1分間の照射では100μW/cm2以下、10秒の照射では600μW/cm2以下の照度となります。
採用しているモジュールでは、照度の強い中央部分に手を入れると1分間で許容限界値となりますが、意図的にUVCを当てようとしない限り、1分間もUVC照射することは無いので、安全に使うことができます。
除菌器の外側に漏れるUVCがあっても、30μW/cm2よりも低い照度ですので、意図的に長時間近づかない限り安全です。
当社の採用している紫外線モジュールは、水銀ほか、環境に問題のある材料は全く使用していませんので環境関連の規制を受けません。
また、この光源はキセノンガスのプラズマ発光を使用しています。
その為、LEDのような点光源と異なり、チューブ状の発光素子から広い放射角で拡散発光します。6本のチューブ発光素子から様々な方向に紫外線が拡散しており、
キーボードのような凹凸があるものでも、影ができにくく、安定した除菌が可能です。
LEDよりも発光効率高く、省エネ型の除菌機器が可能になっています。その為USBからの直給電が可能となりました。
光源寿命は 破損しなければ、紫外線発光量が徐々に減って、1万時間で70%に減ります。
(除菌効果は3割減るが、そのまま使える)
1日あたり、例えば、12台、1日4時間、年間250日だと年間千時間として10年で1万時間の使用で3割の紫外線光量逓減が発生します。
ご購入・お問合わせ
ご購入・お問合わせはこちらから

1社に1台。1棟に1台。
大口採用の際はご遠慮なく
お問い合わせください。